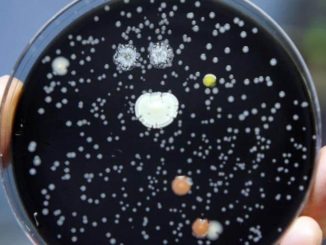

ESTATE: CODACONS LANCIA SERVIZIO CONTRO ABBANDONO DI CANI E ANIMALI
![]()
CITTADINI POSSONO SEGNALARE AL CODACONS CHI LASCIA CANI E GATTI IN STRADA. ASSOCIAZIONE PROVVEDERA’ A DENUNCIARE RESPONSABILI IN PROCURA Anche il Codacons, in occasione delle vacanze estive 2018, aderisce alla campagna contro l’abbandono di cani […]